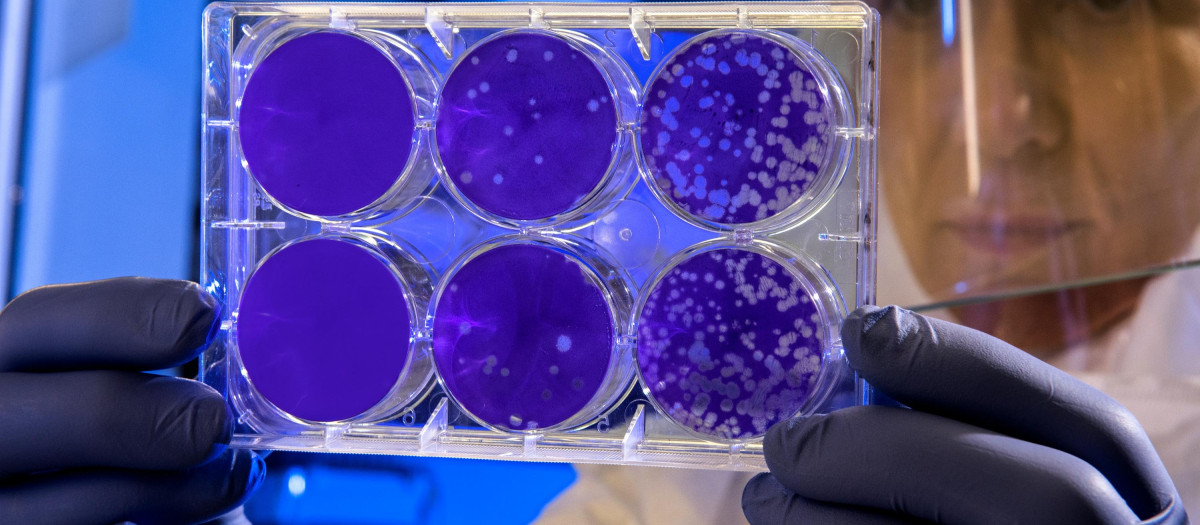
Virus

Virus
La inteligencia artificial cruza una nueva frontera y diseña un virus que mata bacterias
Los investigadores seleccionaron 302 genomas diseñados por la IA y los sintetizaron químicamente
La inteligencia artificial ha dado un salto que redefine los límites entre lo digital y lo biológico. Un grupo de investigadores de la Universidad de Stanford y el Arc Institute de Palo Alto, California, ha logrado que una IA diseñe virus funcionales desde cero. No se trata de ciencia ficción: los resultados, publicados en el servidor científico bioRxiv, describen cómo un modelo generativo fue capaz de crear virus bacteriófagos capaces de infectar bacterias reales.
Durante años, la IA generativa ha sorprendido al mundo con imágenes realistas, videos imposibles y textos indistinguibles de los humanos. Pero el modelo Evo, desarrollado por los científicos Brian Hie y Samuel King, no se alimenta de palabras ni de fotos: aprende de secuencias genéticas. Analizando más de dos millones de genomas virales, Evo fue entrenado para crear nuevos diseños de ADN y ARN con potencial biológico, adelanta el medio Dw en su web.
Su primera prueba fue el bacteriófago phiX174, un virus bien conocido que infecta a la bacteria E. coli. Con solo 11 genes y 5.400 pares de bases, es uno de los genomas más simples de la naturaleza. Lo que parecía un experimento controlado se convirtió en un hallazgo histórico.
Del laboratorio digital al laboratorio físico
Los investigadores seleccionaron 302 genomas diseñados por la IA y los sintetizaron químicamente. El resultado: 16 virus generados por Evo fueron capaces de infectar bacterias reales, replicarse dentro de ellas y destruirlas. Algunos incluso mostraron una eficacia mayor que el virus natural, al atacar distintas cepas de E. coli en lugar de una sola.
«Fue impresionante ver cómo las partículas creadas por la IA cobraban vida bajo el microscopio», comentó Hie a MIT Technology Review. La emoción científica se mezcló con una sensación de asombro –y cierta inquietud– ante el poder de la tecnología.
Promesas médicas y dilemas éticos
El potencial médico es enorme. Virus como estos podrían usarse para desarrollar terapias fágicas capaces de eliminar bacterias resistentes a los antibióticos, uno de los mayores desafíos sanitarios actuales. Sin embargo, el descubrimiento también plantea interrogantes sobre la bioseguridad.
«Si alguien aplicara estos métodos a virus como la viruela o el ántrax, sería alarmante», advirtió el pionero del ADN sintético J. Craig Venter. El riesgo de que herramientas tan potentes sean utilizadas de forma irresponsable es evidente.
Los responsables del estudio aseguran haber tomado precauciones: el modelo Evo excluye cualquier virus que infecte a eucariotas –es decir, organismos complejos como los humanos–, y todo el trabajo se realizó con E. coli y virus considerados seguros en investigación biológica.
Entre el progreso y la precaución
Algunos expertos ven este avance como un paso inevitable en la evolución de la biotecnología. «La IA no hace más que acelerar lo que antes requería años de ensayo y error», señaló Venter. Pero esa misma aceleración podría ser lo que cambie para siempre la relación entre ciencia y control, detalla Dw.
Por ahora, crear organismos más complejos –como bacterias completas– sigue siendo un reto colosal. Según el biólogo Jef Boeke, diseñar una célula viva sería tan complejo que «superaría el número de partículas subatómicas del universo». Los virus, que ni siquiera se consideran seres vivos, son un terreno más manejable… y por eso mismo, más accesible.
Un futuro que ya empezó
El director de Ginkgo Bioworks, Jason Kelly, imagina un porvenir donde los laboratorios automatizados trabajen sin descanso: la IA proponiendo genomas, los robots sintetizándolos y el sistema aprendiendo de cada resultado. «Estados Unidos debería ser el primero en lograrlo», afirma.
Pero no todos comparten su entusiasmo. En un artículo para The Washington Post, los investigadores Tal y Jonathan Feldman advierten que «ya vivimos en un mundo donde la IA puede crear virus funcionales, y no estamos preparados para ello».
Entre la promesa de curar enfermedades y el temor a liberar algo que no podamos controlar, la humanidad enfrenta una nueva pregunta: ¿hasta dónde estamos dispuestos a dejar que la inteligencia artificial juegue con los códigos de la vida?





